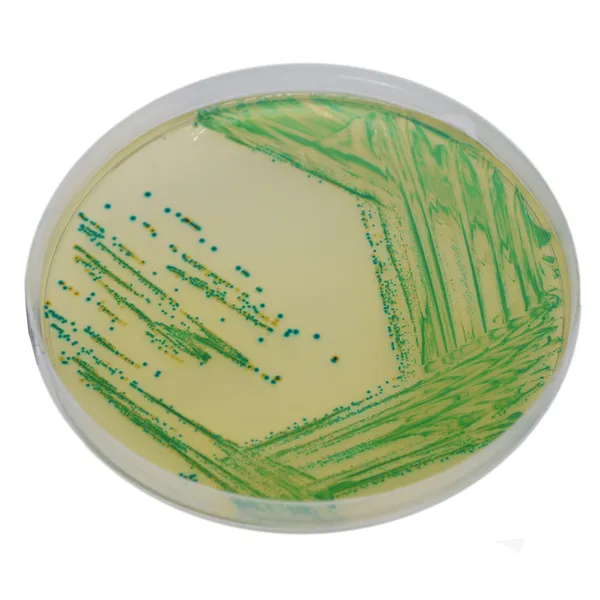
CHROMagar™ Cronobacter

Colonies Appearance

Cronobacter spp.
green to blue

Other Gram (-)
colourless, clear green, black, yellow
Performance
Performance
«Cronobacter is an ubiquitous telluric microorganism found in water, soil, plants, dust and many other living things. Cronobacter has been isolated from many foods of plant or animal origin, both dehydrated, smoked, frozen, fermented, raw and cooked.»
Extracts from ANSES, April 2017
CHROMagar™ Cronobacter is the Chromogenic Cronobacter Isolation (CCI) agar, manufactured in accordance with ISO 22964 standard.
1. ISO 22964 Standard: CHROMagar™ Cronobacter is a chromogenic medium for detection of Cronobacter spp. in food, animal feed and environmental samples according to the ISO 22964 standard.
2. Intense green to blue colonies: Cronobacter spp. will grow in green to blue colonies while most other bacteria will be inhibited or grow in colorless colonies, after incubation at 41.5 °C for 24 h.
Composition

Read more